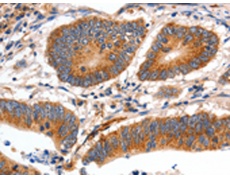
一抗

中文名稱: 兔抗MYH7多克隆抗體
英文名稱: Anti-MYH7 rabbit polyclonal antibody
別 名: CMH1, MPD1, SPMD, SPMM, CMD1S, MYHCB
抗 原: MYH7
儲 存: 冷凍(-20℃)
宿 主: Rabbit
相關(guān)類別: 一抗
反應(yīng)種屬: Human, Mouse, Rat
標(biāo) 記 物: Unconjugate
克隆類型: rabbit polyclonal
技術(shù)規(guī)格
|
Background: |
Muscle myosin is a hexameric protein containing 2 heavy chain subunits, 2 alkali light chain subunits, and 2 regulatory light chain subunits. This gene encodes the beta (or slow) heavy chain subunit of cardiac myosin. It is expressed predominantly in normal human ventricle. It is also expressed in skeletal muscle tissues rich in slow-twitch type I muscle fibers. Changes in the relative abundance of this protein and the alpha (or fast) heavy subunit of cardiac myosin correlate with the contractile velocity of cardiac muscle. Its expression is also altered during thyroid hormone depletion and hemodynamic overloading. Mutations in this gene are associated with familial hypertrophic cardiomyopathy, myosin storage myopathy, dilated cardiomyopathy, and Laing early-onset distal myopathy. |
|
Applications: |
ELISA, IHC |
|
Name of antibody: |
MYH7 |
|
Immunogen: |
Fusion protein of human MYH7 |
|
Full name: |
myosin, heavy chain 7, cardiac muscle, beta |
|
Synonyms: |
CMH1, MPD1, SPMD, SPMM, CMD1S, MYHCB |
|
SwissProt: |
P12883 |
|
ELISA Recommended dilution: |
1000-5000 |
|
IHC positive control: |
Human colon cancer |
|
IHC Recommend dilution: |
10-50 |

 購物車
購物車 幫助
幫助
 021-54845833/15800441009
021-54845833/15800441009